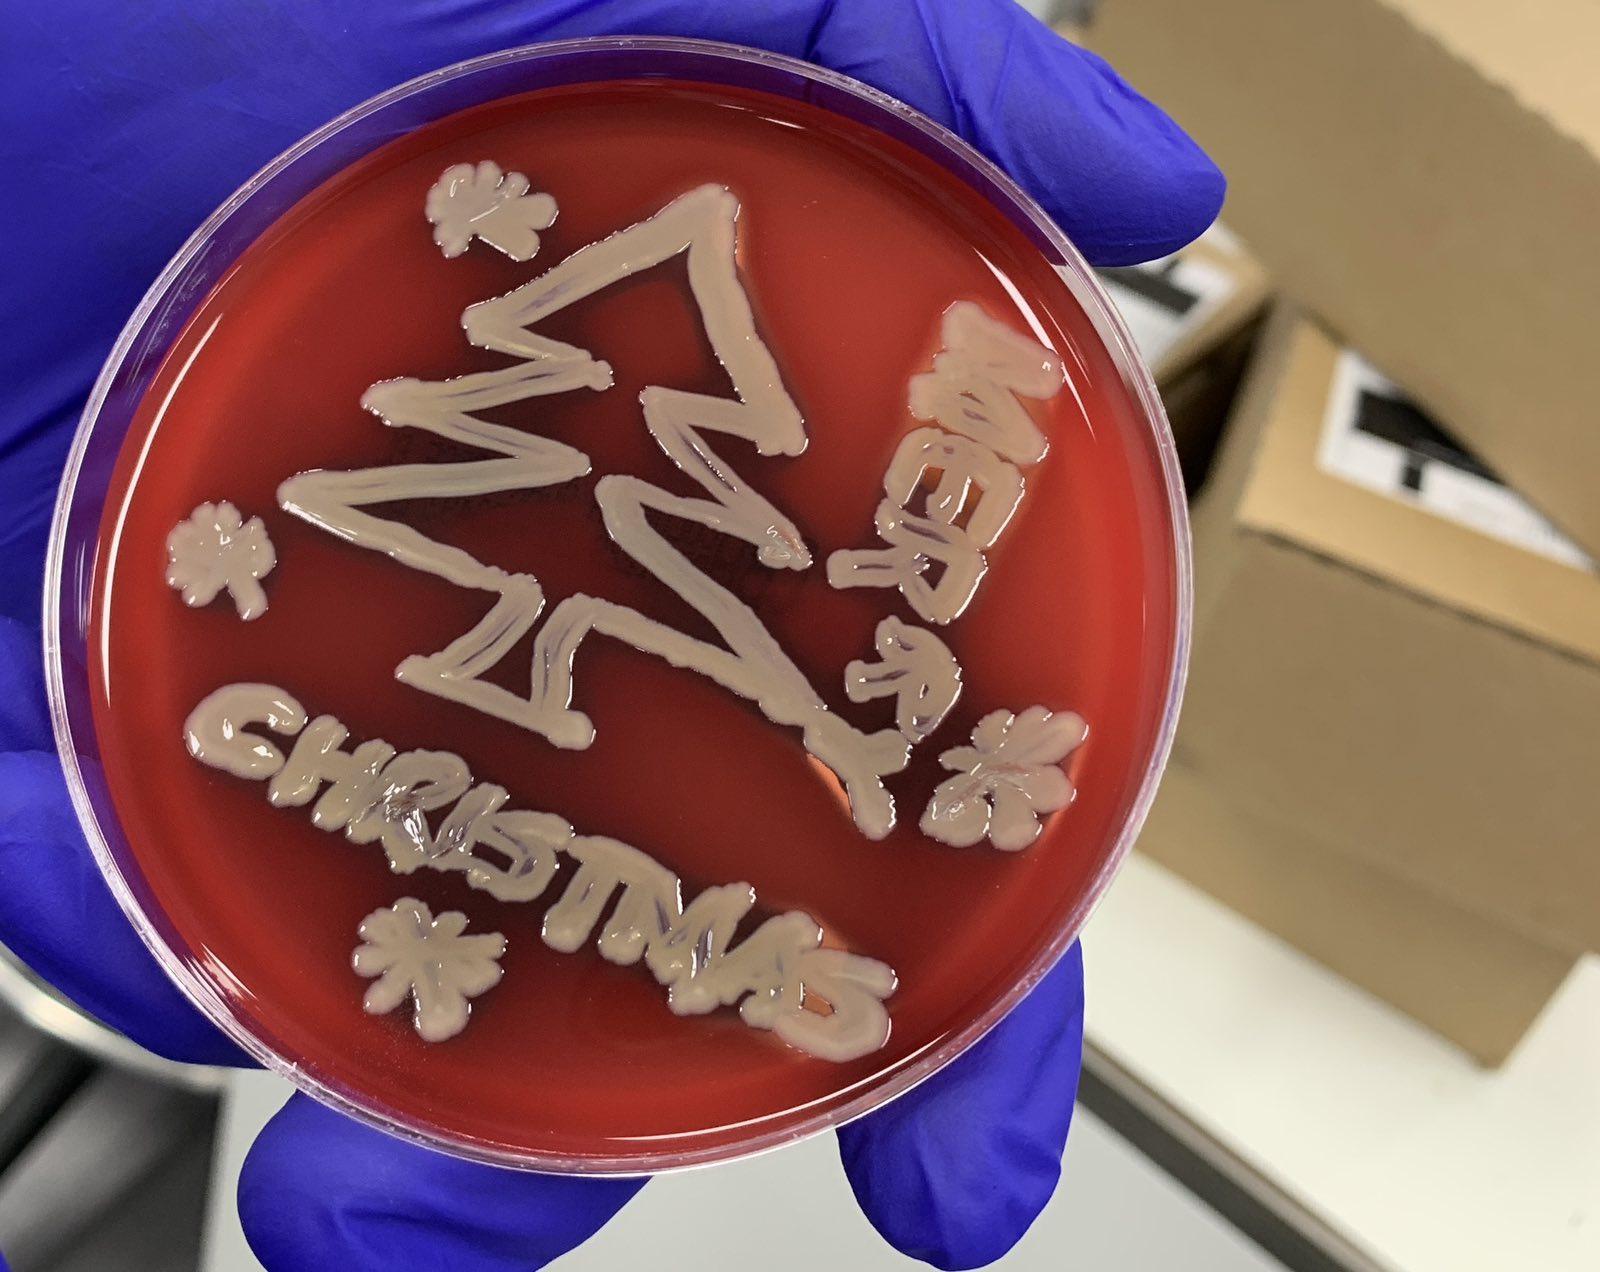

Summer activity 2025 – Great fun with Petanque

European Molecular Imaging Meeting 2025 in Bilbao / Spain … the Party !


Festive Season in the Lab!

World Molecular Imaging Conference 2023 in Prague / Czech Republic






European Molecular Imaging Meeting 2023 in Salzburg / Austria…



European Molecular Imaging Meeting 2023 in Salzburg / Austria … the Afterparty !

































Our team trying to trace therapeutic cells to a nasty tumour near Central London on a typical British summer day.


Alessia graduating in KCL’s Vivienne Westwood robe
